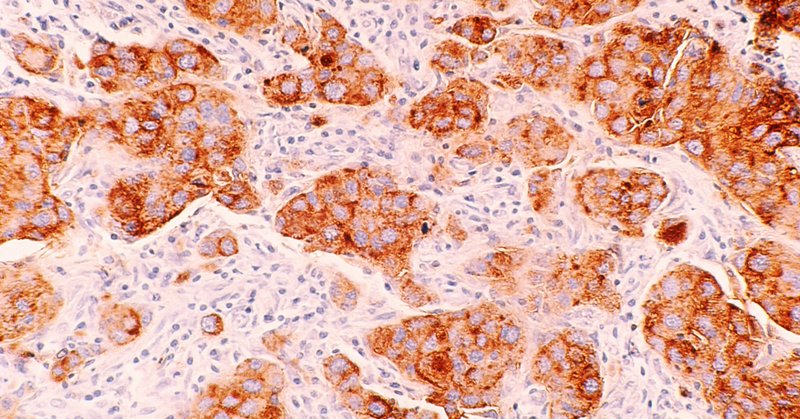
Tweet card summary image

Oge Marques
@ProfessorOge
Followers
1K
Following
12K
Media
257
Statuses
2K
Sr. Strategic Researcher Engagement Manager at NVIDIA ◼︎Affiliate Professor at FAU ◼︎Book author & book series editor
Joined May 2011
📚 New Book Announcement: "AI for Radiology" 📚 I hope my latest book will become a valuable resource for medical professionals, computer scientists, and anyone interested in AI's clinical applications. https://t.co/aSy1tlkiz0
#AI #Radiology #MedicalImaging
0
1
10
NVIDIA’s Graduate Fellowship Program is now accepting applications for the 2026–2027 academic year. Selected Ph.D. students receive tuition and stipend coverage up to $60K, plus mentorship and technical support from top NVIDIA researchers during an NVIDIA internship. If you’re
7
59
220
We're hiring! We have openings in 9 subspecialties, including Neuroradiology, Breast Imaging, IR, Pediatrics & MSK. Join a leading academic department committed to clinical excellence, research & education. https://t.co/dB8NZLnKI2
0
1
15
Our 2022 paper on #ai and #medical #education has reached the 100-citation milestone! https://t.co/qiLpautS3Q
scholar.google.com
J Grunhut, O Marques, ATM Wyatt, JMIR medical education, 2022 - Cited by 162
0
0
1
Our paper on A.I. agents for healthcare just published @natBME @pranavrajpurkar Michael Moritz free access https://t.co/tbn9pQzz43
12
156
510
📣 Announced at #GTC25: NVIDIA cuML now accelerates scikit-learn, the most popular machine learning library, up to 50x with zero code changes. Zero code change acceleration is also supported for HDBSCAN and UMAP. Read the announcement blog: https://t.co/uPz4L1tDZr
4
29
157
You heard it at #SC24, NVIDIA #BioNeMo Framework is now open-source. Researchers worldwide can accelerate the development of life-saving treatments by tapping into the collection of accelerated programming tools for biomolecular research. #drugdiscovery
https://t.co/MIoAMd7ka8
0
1
2
Hugging Face and NVIDIA are teaming up to advance robotics. By combining Hugging Face's LeRobot with NVIDIA AI, Omniverse, and #robotics technology, we're enabling researchers & developers to innovate. #CoRL2024
blogs.nvidia.com
At the Conference for Robot Learning (CoRL) in Munich, Germany, Hugging Face and NVIDIA announced a collaboration to accelerate robotics research and development by bringing together their open-sou...
0
0
3
Learn more about the new NVIDIA AI Blueprint for video search and summarization, which speeds up the development of visual AI agents. It uses #VLM, LLMs, and the latest RAG techniques for long-form video understanding. https://t.co/BEIuEW4URh
0
0
0
Congratulations to all NVIDIA partners and Inception members featured in Time Magazine's Best Inventions of 2024.
time.com
Groundbreaking innovations that are making the world better, smarter, and a little more fun
0
0
0
Discover how to build powerful multimodal visual AI agents with NVIDIA NIM. Get hands-on with Jupyter notebooks for applications like streaming video alerts, structured text extraction, multimodal search, and few-shot classification.
developer.nvidia.com
The exponential growth of visual data—ranging from images to PDFs to streaming videos—has made manual review and analysis virtually impossible. Organizations are struggling to transform this data...
0
3
11
🔬 New research from @UTSWMedCenter creates a 4D deep learning #AI model for identifying #breastcancer metastasis using only MRI and clinical data, for early detection without invasive biopsies.🩺 🔗 Learn more: https://t.co/YLVw3yH23o
developer.nvidia.com
A new deep learning model could reduce the need for surgery when diagnosing whether cancer cells are spreading, including to nearby lymph nodes—also known as metastasis. Developed by researchers from…
0
0
1
🙌 Join a series of free, virtual faculty development workshops w/ training in #deeplearning, #generativeAI and #LLMs, data science, & accelerated computing. Register now ➡️ https://t.co/4dQow7SdrU
https://t.co/OmJdtomVo6
0
0
0
See the NVIDIA technical blog on how we are optimizing the 🦙 Llama 3.2 collection of open models with NVIDIA NIM microservices to accelerate flexible #AI experiences: https://t.co/Hf5Qat9Cpe
0
0
1
Experience high-efficiency NVIDIA Llama-3.1-Nemotron-51B - a NAS-optimized model achieving 2x throughput while preserving accuracy runs on a single H100 GPU. Technical deep dive ➡️
developer.nvidia.com
Today, NVIDIA released a unique language model that delivers an unmatched accuracy-efficiency performance. Llama 3.1-Nemotron-51B, derived from Meta’s Llama-3.1-70B, uses a novel neural architecture…
0
0
0
Try Hive’s AI-Generated Image Classification model, the latest powerful image classification tool for identifying and managing AI-generated content, on https://t.co/6KfRHKiCVY today. https://t.co/h0bedEKxnM
0
0
1
Leading U.S. medical centers and research institutes are tapping into federated learning to detect cancer. This research collaboration uses NVIDIA FLARE and MONAI for secure, flexible AI model training for tumor segmentation. #NVIDIAAcademicGrant
blogs.nvidia.com
A committee of experts from top U.S. medical centers and research institutes is harnessing NVIDIA-powered federated learning to evaluate the impact of federated learning and AI-assisted annotation to...
0
0
0
Generate code with Abacus AI’s Dracarys Large Language Model Dracarys, fine-tuned from Llama 3.1 70B and available from NVIDIA NIM microservice, supports a variety of applications, including data analysis, text summarization, and multi-language support. https://t.co/iScum29d2B
0
0
1
Generate images with consistent characters without fine tuning or training. Consistory maintains subject consistency between text-to-image generations on pretrained models. Explore: https://t.co/krInXuWzI7
https://t.co/XMAETL4PEx
0
0
1
📚 Introducing the new Generative AI Teaching Kit for educators developed w/ Professor Sam Raymond from @dartmouth. Enable students to explore the field of #GenAI w/ hands-on experimentation in #LLMs, diffusion models, & more. https://t.co/9PS487iZlc
0
1
1
💫Excited to share our new study: “Uncovering Knowledge Gaps in Radiology Report Generation Models through Knowledge Graphs”. We’ve developed a system ReXKG to extract structured information from radiology reports, building a comprehensive knowledge graph for in-depth model
2
8
47